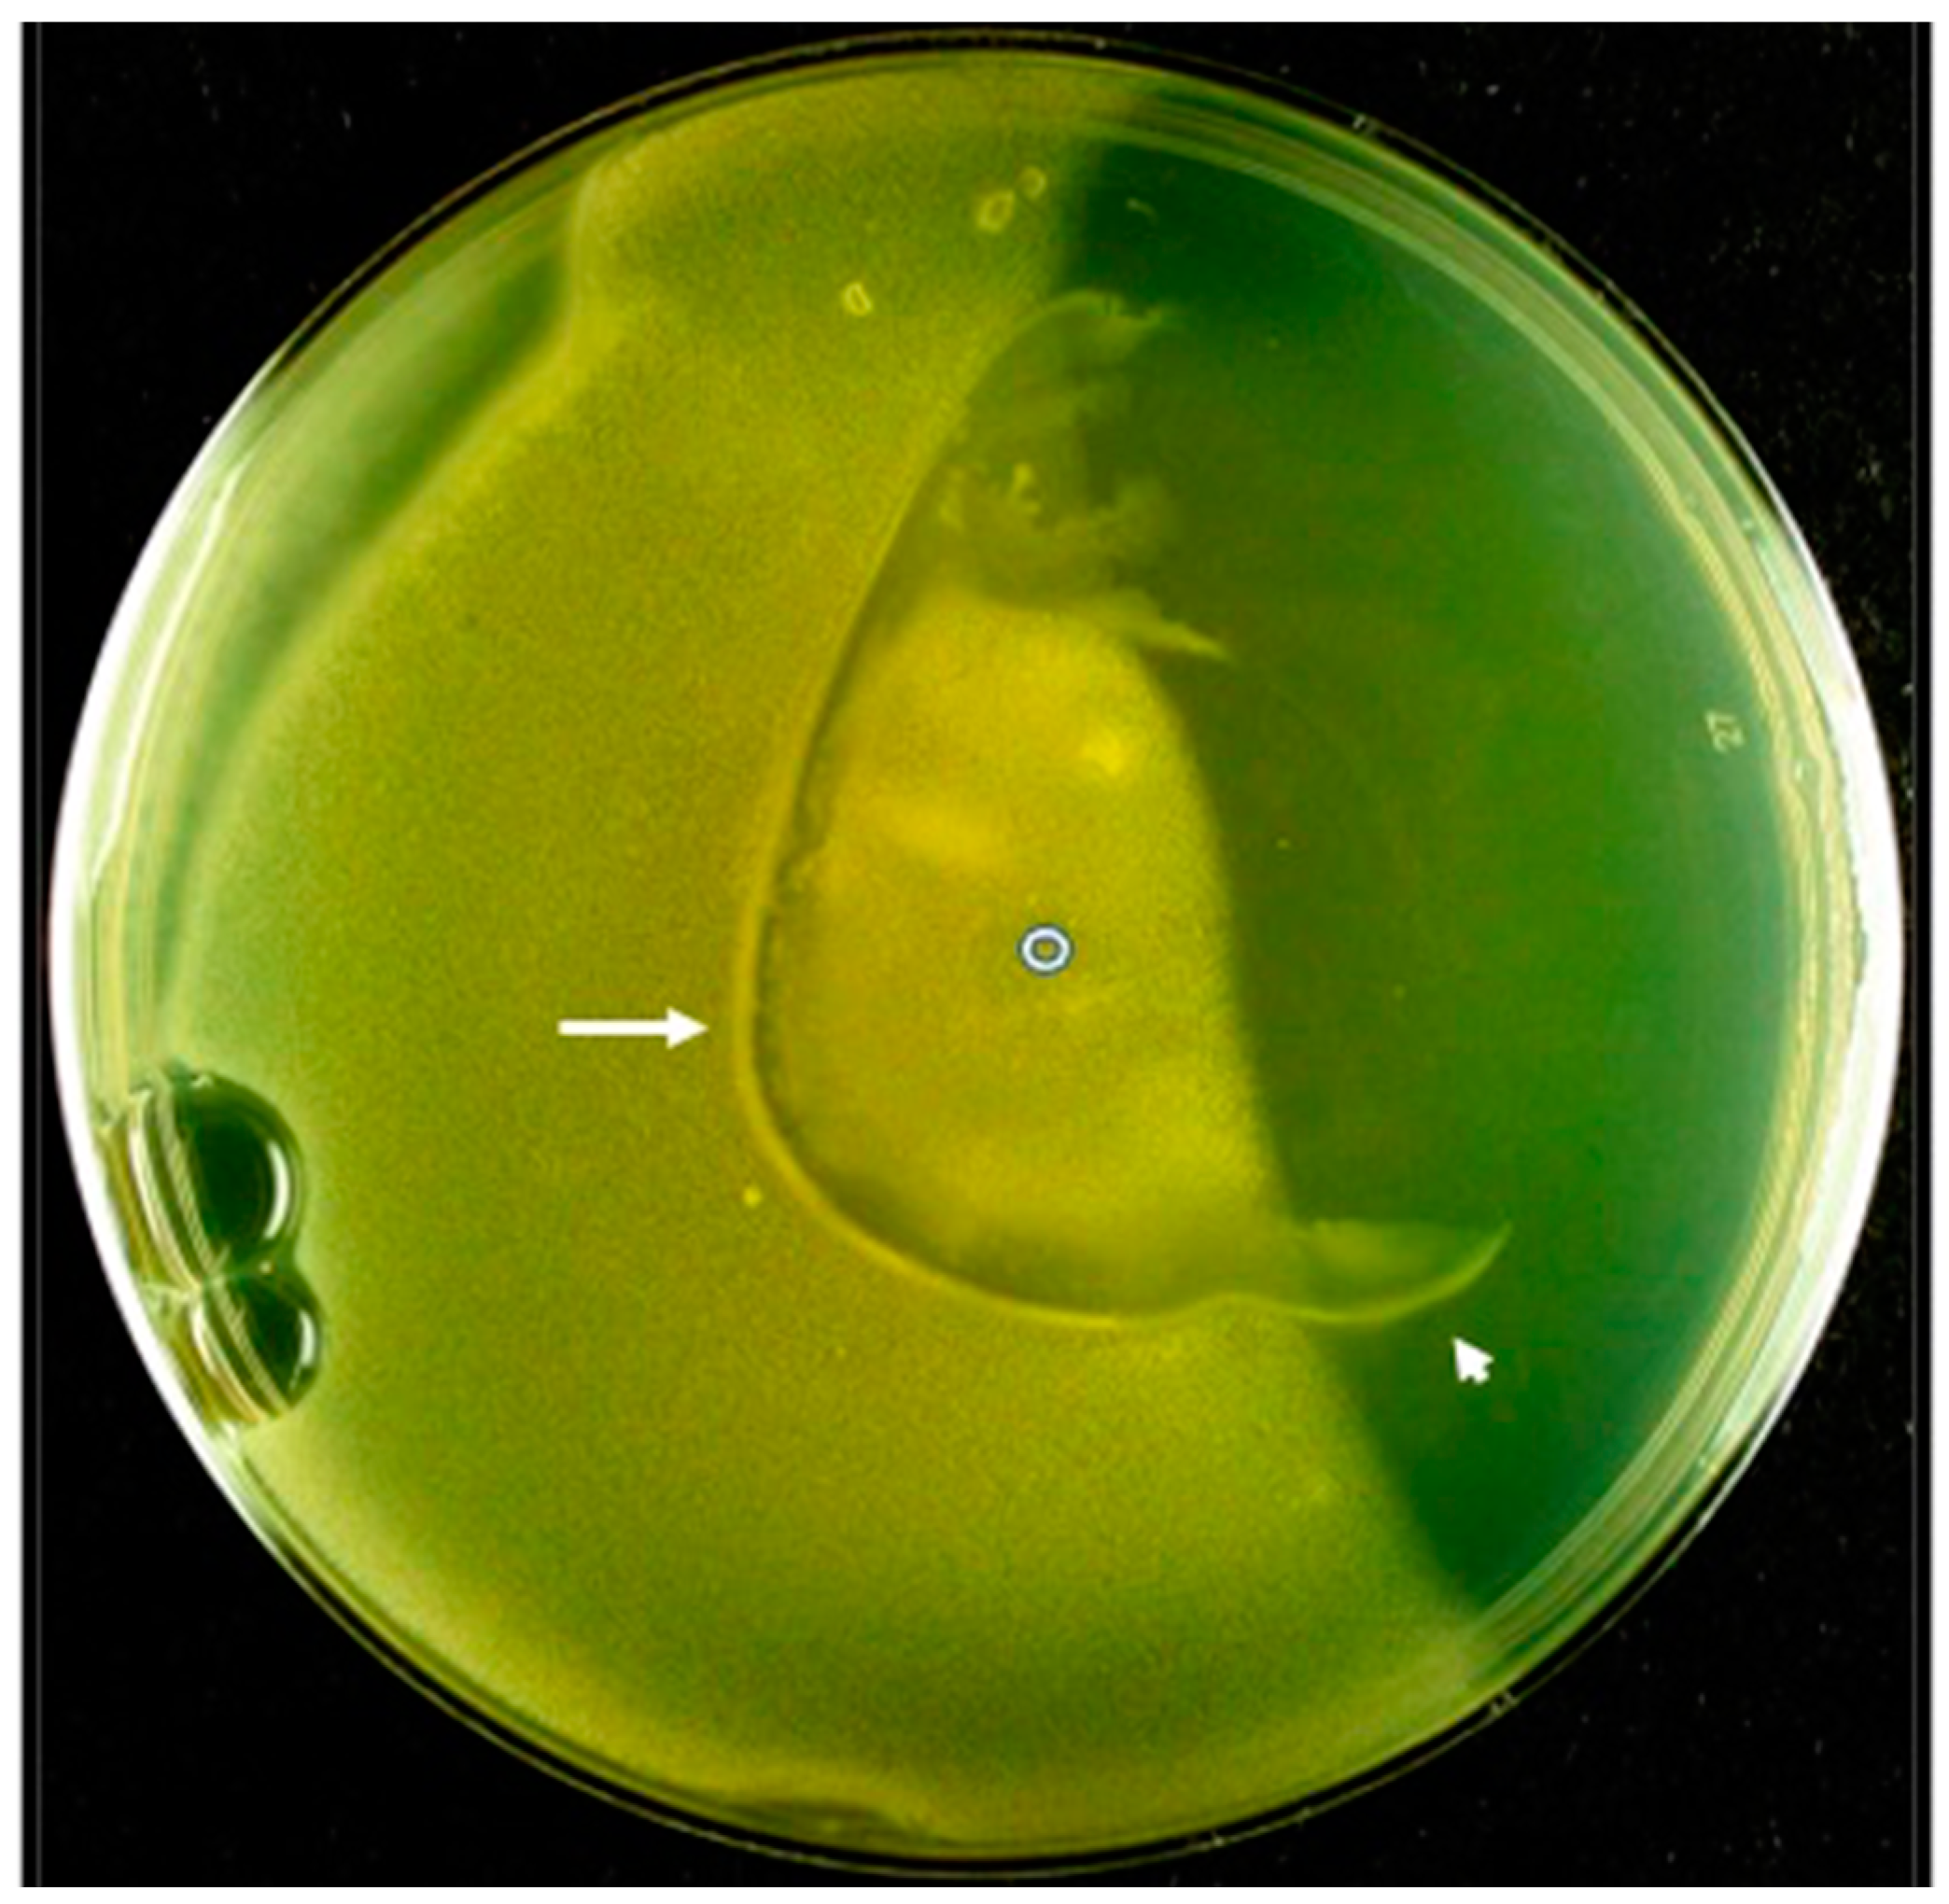
Viruses 15 02409 g003

Extracellular Interaction of Bacillus thuringiensis, ATP and Phage 0105phi7-2: A Potential New Anti-Bacterial Strategy
Abstract
1. Introduction
2. Materials and Methods
2.1. Phage and Host
2.2. Gelled Media and Generation of an Extracellular [ATP] Gradient
2.3. Testing the Effects of an [ATP] Gradient on Bacteria and Phage
3. Results
3.1. Effects of an Extracellular [ATP] Gradient vs. [ATP] in the Lower Agar Wedge
3.2. Effects of ATP at Uniform Concentration
3.3. Location of Infective Phage 0105phi7-2 in the [ATP] Gradient
4. Discussion
Author Contributions
Funding
Institutional Review Board Statement
Informed Consent Statement
Data Availability Statement
Acknowledgments
Conflicts of Interest
References
- Sharma, S.; Mohler, J.; Mahajan, S.D.; Schwartz, S.A.; Bruggemann, L.; Aalinkeel, R. Microbial biofilm: A review on formation, infection, antibiotic resistance, control measures, and innovative treatment. Microorganisms 2023, 11, 1614. [Google Scholar] [CrossRef]
- Liu, S.; Lu, H.; Zhang, S.; Shi, Y.; Chen, Q. Phages against pathogenic bacterial biofilms and biofilm-based infections: A review. Pharmaceutics 2022, 14, 427. [Google Scholar] [CrossRef]
- Kuang, X.; Chen, V.; Xu, X. Novel approaches to the control of oral microbial biofilms. Biomed. Res. Int. 2018, 2018, 498932. [Google Scholar] [CrossRef]
- Mohamad, F.; Alzahrani, R.R.; Alsaadi, A.; Alrfaei, B.M.; Yassin, A.E.B.; Alkhulaifi, M.M.; Halwani, M. An explorative review on advanced approaches to overcome bacterial resistance by curbing bacterial biofilm formation. Infect. Drug Resist. 2023, 16, 19–49. [Google Scholar] [CrossRef]
- Donlan, R.M. Biofilms: Microbial life on surfaces. Emerg. Infect. Dis. 2002, 8, 881–890. [Google Scholar] [CrossRef]
- Whitchurch, C.B. Extracellular DNA required for bacterial biofilm formation. Science 2002, 295, 1487. [Google Scholar] [CrossRef]
- Xi, C.; Wu, J. dATP/ATP, a multifunctional nucleotide, stimulates bacterial cell lysis, extracellular DNA release and biofilm development. PLoS ONE 2010, 5, e13355. [Google Scholar] [CrossRef]
- Ding, Q.; Tan, K.S. The danger signal extracellular ATP is an inducer of Fusobacterium nucleatum biofilm dispersal. Front. Cell Infect. Microbiol. 2016, 6, 155. [Google Scholar] [CrossRef]
- Guttenplan, S.B.; Kearns, D.B. Regulation of flagellar motility during biofilm formation. FEMS Microbiol. Rev. 2013, 37, 849–871. [Google Scholar] [CrossRef]
- Liaqat, I.; Mirza, S.A.; Iqbal, R.; Ali, N.M.; Saleem, G.; Majid, S.; Shahid, M. Flagellar motility plays important role in biofilm formation of Bacillus cereus and Yersinia enterocolitica. Pak. J. Pharm. Sci. 2018, 5, 2047–2052. [Google Scholar]
- Houry, A.; Briandet, R.; Aymerich, S.; Gohar, M. Involvement of motility and flagella in Bacillus cereus biofilm formation. Microbiology 2010, 156 Pt 4, 1009–1018. [Google Scholar] [CrossRef]
- Okshevsky, M.; Louw, M.G.; Lamela, E.O.; Nilsson, M.; Tolker-Nielsen, T.; Meyer, R.L. A transposon mutant library of Bacillus cereus ATCC 10987 reveals novel genes required for biofilm formation and implicates motility as an important factor for pellicle-biofilm formation. Microbiologyopen 2018, 7, e00552. [Google Scholar] [CrossRef]
- Hennessey, T.M. Responses of the ciliates Tetrahymena and Paramecium to external ATP and GTP. Purinergic Signal 2005, 1, 101–110. [Google Scholar] [CrossRef][Green Version]
- Brette, R. Integrative neuroscience of paramecium, a “swimming neuron”. eNeuro 2021, 8, ENEURO.0018-21.2021. [Google Scholar] [CrossRef]
- Roberts, S.M.; Aldis, M.; Wright, E.T.; Gonzales, C.B.; Lai, Z.; Weintraub, S.T.; Hardies, S.C.; Serwer, P. Siphophage 0105phi7-2 of Bacillus thuringiensis: Novel propagation, DNA, and genome-implied assembly. Int. J. Mol. Sci. 2023, 24, 8941. [Google Scholar] [CrossRef]
- Abedon, S.T. Bacteriophage adsorption: Likelihood of virion encounter with bacteria and other factors affecting rates. Antibiotics 2023, 12, 723. [Google Scholar] [CrossRef]
- SeaKem® Gold Agarose. Available online: https://bioscience.lonza.com/lonza_bs/US/en/Electrophoresis/p/000000000000182217/SeaKem%C2%AE-Gold-Agarose (accessed on 24 August 2023).
- Rexroat, M.A.; Oberly, T.J.; Bewsey, B.J.; Garriott, M.L. The gradient plate assay: A modified Ames assay used as a prescreen for the identification of bacterial mutagens. Mutat. Res. 1995, 341, 185–192. [Google Scholar] [CrossRef]
- Hunt, D.E.; Sandham, H.J. Improved agar gradient-plate technique. Appl. Microbiol. 1969, 17, 329–330. [Google Scholar] [CrossRef]
- Liu, Y.; Li, J.; Du, J.; Hu, M.; Bai, H.; Qi, J.; Gao, C.; Wei, T.; Su, H.; Jin, J.; et al. Accurate assessment of antibiotic susceptibility and screening resistant strains of a bacterial population by linear gradient plate. Sci. China Life Sci. 2011, 54, 953–960. [Google Scholar] [CrossRef]
- Tatano, Y.; Kanehiro, Y.; Sano, C.; Shimizu, T.; Tomioka, H. ATP exhibits antimicrobial action by inhibiting bacterial utilization of ferric ions. Sci. Rep. 2015, 5, 8610. [Google Scholar] [CrossRef]
- Ivanova, E.P.; Alexeeva, Y.V.; Pham, D.K.; Wright, J.P.; Nicolau, D.V. ATP level variations in heterotrophic bacteria during attachment on hydrophilic and hydrophobic surfaces. Int. Microbiol. 2006, 9, 37–46. [Google Scholar] [PubMed]
- Spari, D.; Beldi, G. Extracellular ATP as an inter-kingdom signaling molecule: Release mechanisms by bacteria and its implication on the host. Int. J. Mol. Sci. 2020, 21, 5590. [Google Scholar] [CrossRef] [PubMed]
- Coraça-Huber, D.C.; Dichtl, S.; Steixner, S.; Nogler, M.; Weiss, G. Iron chelation destabilizes bacterial biofilms and potentiates the antimicrobial activity of antibiotics against coagulase-negative Staphylococci. Pathog. Dis. 2018, 76, fty052. [Google Scholar] [CrossRef] [PubMed]
- Hyman, P. Phages for phage therapy: Isolation, characterization, and host range breadth. Pharmaceuticals 2019, 12, 35. [Google Scholar] [CrossRef]
- Myers, J.; Davis, J., II; Lollo, M.; Hudec, G.; Hyman, P. More’s the same—Multiple hosts do not select for broader host range phages. Viruses 2023, 15, 518. [Google Scholar] [CrossRef]

Disclaimer/Publisher’s Note: The statements, opinions and data contained in all publications are solely those of the individual author(s) and contributor(s) and not of MDPI and/or the editor(s). MDPI and/or the editor(s) disclaim responsibility for any injury to people or property resulting from any ideas, methods, instructions or products referred to in the content. |
© 2023 by the authors. Licensee MDPI, Basel, Switzerland. This article is an open access article distributed under the terms and conditions of the Creative Commons Attribution (CC BY) license (https://creativecommons.org/licenses/by/4.0/).
Share and Cite
Ritter, S.; Wright, E.T.; Serwer, P. Extracellular Interaction of Bacillus thuringiensis, ATP and Phage 0105phi7-2: A Potential New Anti-Bacterial Strategy. Viruses 2023, 15, 2409. https://doi.org/10.3390/v15122409
Ritter S, Wright ET, Serwer P. Extracellular Interaction of Bacillus thuringiensis, ATP and Phage 0105phi7-2: A Potential New Anti-Bacterial Strategy. Viruses. 2023; 15(12):2409. https://doi.org/10.3390/v15122409
Chicago/Turabian StyleRitter, Samantha, Elena T. Wright, and Philip Serwer. 2023. "Extracellular Interaction of Bacillus thuringiensis, ATP and Phage 0105phi7-2: A Potential New Anti-Bacterial Strategy" Viruses 15, no. 12: 2409. https://doi.org/10.3390/v15122409
APA StyleRitter, S., Wright, E. T., & Serwer, P. (2023). Extracellular Interaction of Bacillus thuringiensis, ATP and Phage 0105phi7-2: A Potential New Anti-Bacterial Strategy. Viruses, 15(12), 2409. https://doi.org/10.3390/v15122409

